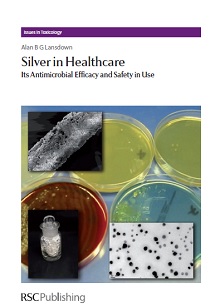
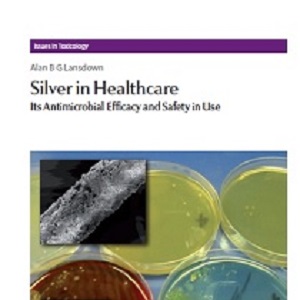

کتاب لاتین نقره در مراقبت سلامت: اثربخشی آنتی میکروبیال و ایمنی آن در استفاده (۲۰۱۰)
نقره یکی از عناصر شیمیایی است و جزء عناصر نسبتا کمیاب محسوب میگردد. کتاب لاتین نقره در مراقبت سلامت: اثربخشی آنتی میکروبیال و ایمنی آن در استفاده به بیان مطالبی در زمینه شیمی و متابولیسم نقره و مطالب دیگر مرتبط با آن پرداخته است.
مشخصات کتاب لاتین نقره در مراقبت سلامت: اثربخشی آنتی میکروبیال و ایمنی آن در استفاده
نام کتاب: Silver in Healthcare: Its Antimicrobial Efficacy and Safety in Use
نویسنده: Alan B. G. Lansdown
زبان: انگلیسی
تاریخ چاپ: ۲۰۱۰
ویراست: اول
ناشر: RSC Publishing
تعداد فصول: ۱۰ فصل
تعداد صفحات: ۲۷۵ صفحه
حجم فایل: ۳ مگابایت
معرفی کتاب لاتین نقره در مراقبت سلامت: اثربخشی آنتی میکروبیال و ایمنی آن در استفاده
کتاب لاتین نقره در مراقبت سلامت: اثربخشی آنتی میکروبیال و ایمنی آن در استفاده توسط آلان بی. جی. لانزداون نوشته شده و در ۲۰۱۰ به چاپ رسیده است و جزء مجموعه کتابهای مسائلی در سم شناسی محسوب میگردد. این کتاب در ۱۰ فصل سازمان دهی شده است که عناوین فصول این کتاب را در زیر مشاهده میکنید:
فصل اول: نقره در سلامت و بیماری
فصل دوم: نقره و ترکیبات آن، شیمی و واکنش متقابل زیستی
فصل سوم: برداشت و متابولیسم نقره در بدن انسان
فصل چهارم: نقره به عنوان یک آنتی بیوتیک: مشکلات مقاومت
فصل پنجم: نقره در ابزارهای پزشکی: تکنولوژی و اثربخشی آنتی میکروبیال
فصل ششم: نقره به عنوان یک آنتی بیوتیک در سیستمهای آب
فصل هفتم: تکنولوژی نقره و Antibiotic Textiles
فصل هشتم: سم شناسی نقره
فصل نهم: نقره و ارگانهای حس ویژه
فصل دهم: فکر نهایی: چه مقدار نقره بسیار زیاد است؟
خرید و دانلود کتاب لاتین نقره در مراقبت سلامت: اثربخشی آنتی میکروبیال و ایمنی آن در استفاده
شما میتوانید با خرید و دانلود کتاب لاتین نقره در مراقبت سلامت: اثربخشی آنتی میکروبیال و ایمنی آن در استفاده از مزایای این خرید استفاده نمایید که عبارتند از:
۱- متن کامل کتاب لاتین راهنمایی برای نقره در مراقبت سلامت: اثربخشی آنتی میکروبیال و ایمنی آن در استفاده به صورت pdf
۲- دسترسی سریع به لینک دانلود پس از پرداخت
۳- پاسخگویی سریع به سوالات پس از خرید

دیدگاه خود را ثبت کنید
تمایل دارید در گفتگوها شرکت کنید؟در گفتگو ها شرکت کنید.